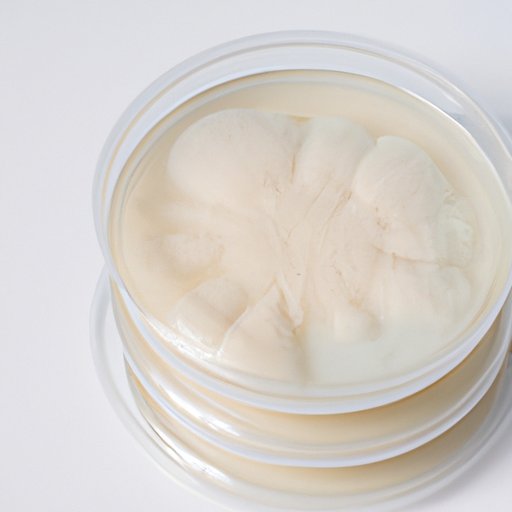

Introduction
Agar, also known as agar-agar, is a type of gelatinous substance derived from seaweed which is commonly used in science experiments. It is often used as a growing medium for bacteria and fungi cultures, and can also be used as a thickener or stabilizer in food products. For these reasons, it is an important ingredient for many science experiments and lab activities.
In this article, we will explore the different options for where to buy agar for science experiments. We will cover the top five online retailers for purchasing agar, tips for finding quality agar on a budget, a guide to the different types of agar available, advice for buying bulk agar, and the best local sources for purchasing agar. By the end of this article, you will have all the information you need to make an informed decision when buying agar for your science experiments.

Review of Top 5 Online Retailers for Buying Agar for Science Experiments
When it comes to buying agar for science experiments, there are several online retailers that offer a wide selection of agar products at competitive prices. The following is a review of the top five online retailers for purchasing agar for science experiments.
1. Amazon – Amazon offers a wide selection of agar products from different manufacturers, including both powder and pre-made solutions. Prices range from inexpensive to mid-range, depending on the product. Shipping is usually free for Amazon Prime members.
2. Fisher Scientific – Fisher Scientific is one of the leading suppliers of laboratory equipment and supplies. They offer a variety of agar products, including powders, pre-made solutions, and petri dishes. Prices are generally mid-range to high-end. Shipping costs vary depending on the size of the order.
3. Carolina Biological Supply Company – Carolina Biological Supply Company specializes in providing educational materials and supplies for science classrooms. They offer a wide selection of agar products at mid-range to high-end prices. Shipping costs vary depending on the size of the order.
4. VWR International – VWR International is another leading supplier of laboratory equipment and supplies. They offer a variety of agar products, including powders, pre-made solutions, and petri dishes. Prices range from mid-range to high-end. Shipping costs vary depending on the size of the order.
5. Sigma-Aldrich – Sigma-Aldrich is a global life science and technology company that provides a range of products for research and development. They offer a wide selection of agar products at mid-range to high-end prices. Shipping costs vary depending on the size of the order.
How to Source Quality Agar for Science Experiments on a Budget
If you are looking to purchase agar for science experiments but are on a tight budget, there are some tips and strategies you can use to help you find quality agar at an affordable price. Here are a few tips for sourcing quality agar on a budget:
1. Comparison shop – Take the time to compare prices between different online retailers and local stores to make sure you are getting the best deal. Don’t forget to factor in shipping costs when comparing prices.
2. Look for sales – Many online retailers offer discounts and sales throughout the year, so keep an eye out for deals when shopping for agar.
3. Buy in bulk – Purchasing large quantities of agar can save you money in the long run. However, make sure you have a plan for storing and using the agar before making a bulk purchase.

A Guide to the Different Types of Agar Available for Science Experiments
When buying agar for science experiments, it is important to know the different types of agar available and their advantages and disadvantages. The most common types of agar used in science experiments are:
1. Nutrient agar – Nutrient agar is a general-purpose medium that is suitable for culturing a wide variety of microorganisms. It contains a mixture of nutrients, such as peptone, beef extract, yeast extract, and sodium chloride. It is relatively inexpensive and easy to use.
2. MacConkey agar – MacConkey agar is a selective and differential medium used for the isolation and identification of Gram-negative bacteria. It is formulated with bile salts and crystal violet, which inhibit the growth of Gram-positive bacteria and allow for the differentiation of lactose-fermenting bacteria.
3. Potato dextrose agar – Potato dextrose agar is a general-purpose medium used for the cultivation of yeasts and molds. It contains potato infusion and dextrose, which provide nutrition for the growth of the microorganisms. It is more expensive than nutrient agar but is ideal for culturing fastidious organisms.
4. Sabouraud dextrose agar – Sabouraud dextrose agar is a selective medium used for the isolation and identification of fungi. It contains a low pH buffer system, which inhibits the growth of bacteria, and dextrose, which provides nutrition for the fungi. It is more expensive than other types of agar but is necessary for culturing fungi.
Tips for Buying Bulk Agar for Science Experiments
If you are planning on purchasing bulk agar for science experiments, there are a few things you should consider before making the purchase. Here are some tips for buying bulk agar:
1. Determine your needs – Before making a bulk purchase, determine how much agar you need and what type of agar you need for your experiments. This will help you find the best deal and ensure you don’t overspend.
2. Consider storage – Bulk agar should be stored in an airtight container in a cool, dry place. Make sure you have adequate storage space before making a bulk purchase.
3. Check expiration dates – Bulk agar has a shelf life of about two years. Make sure to check the expiration date before making a purchase.

The Best Local Sources for Agar for Science Experiments
In addition to online retailers, there are several local sources for purchasing agar for science experiments. Popular local retailers include science supply stores, hobby stores, and health food stores. Many of these stores offer a wide selection of agar products at competitive prices. Additionally, buying from local sources allows you to inspect the product in person and ask questions if needed.
Conclusion
Agar is an essential ingredient for many science experiments and lab activities. In this article, we explored the different options for where to buy agar for science experiments. We reviewed the top five online retailers for purchasing agar, provided tips for finding quality agar on a budget, and gave a guide to the different types of agar available. We also discussed tips for buying bulk agar and the best local sources for purchasing agar. With this information, you will be able to make an informed decision when buying agar for your science experiments.
(Note: Is this article not meeting your expectations? Do you have knowledge or insights to share? Unlock new opportunities and expand your reach by joining our authors team. Click Registration to join us and share your expertise with our readers.)